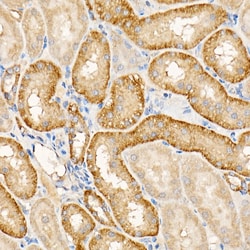
Invitrogen TES Polyclonal Antibody 100 &mu;L; Unconjugated:Antibodies,

Learn More
Invitrogen™ TES Polyclonal Antibody


Rabbit Polyclonal Antibody
Brand: Invitrogen™ PA5117087
Description
Positive Samples: HeLa, 22Rv1, Rat ovary Immunogen sequence: MDLENKVKKM GLGHEQGFGA PCLKCKEKCE GFELHFWRKI CRNCKCGQEE HDVLLSNEED RKVGKLFEDT KYTTLIAKLK SDGIPMYKRN VMILTNPVAA KKNVSINTVT YEWAPPVQNQ ALARQYMQML PKEKQPVAGS EGAQYRKKQL AKQLPAHDQD PSKCHELSPR EVKEMEQFVK KYKSEALGVG DVKLPCEMDA QGPKQMNIPG GDRSTPAAVG AMEDKSAEHK RTQYSCYCCK LSMKEGDPAI YAERAGYDKL.
TES maps to a common fragile site on chromosome 7q31.2 designated FRA7G and this gene is similar to mouse Testin, a testosterone-responsive gene encoding a Sertoli cell secretory protein containing three LIM domains. LIM domains are double zinc-finger motifs that mediate protein-protein interactions between transcription factors, cytoskeletal proteins and signaling proteins. Multiple protein isoforms are encoded by transcript variants of the TES gene and Cancer-associated chromosomal changes often involve regions containing fragile sites involving the TES gene.
Specifications
| TES | |
| Polyclonal | |
| Unconjugated | |
| TES | |
| D6Ertd352e; TES; Tes1; TES1/TES2; Tes2; TESS; TESS-2; testin; testin 2; testin LIM domain protein; testin2; testis derived transcript; testis derived transcript (3 LIM domains) | |
| Rabbit | |
| Affinity Chromatography | |
| RUO | |
| 26136, 500040 | |
| -20°C, Avoid Freeze/Thaw Cycles | |
| Liquid |
| ELISA, Immunohistochemistry (Paraffin), Western Blot | |
| 0.23 mg/mL | |
| PBS with 50% glycerol and 0.01% thimerosal; pH 7.3 | |
| Q2LAP6, Q9UGI8 | |
| TES | |
| Recombinant fusion protein containing a sequence corresponding to amino acids 1-260 of human TES (NP_0564561). | |
| 100 μL | |
| Primary | |
| Human, Rat | |
| Antibody | |
| IgG |
Your input is important to us. Please complete this form to provide feedback related to the content on this product.